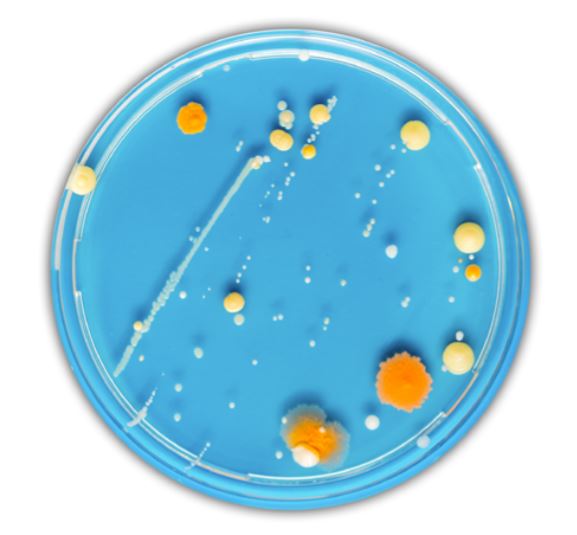
Microbial Solutions

Quality Control Microbiology Testing Solutions
Protecting the integrity of your products demands rigorous quality control, a critical task made easier with the help of a reliable partner. Our microbial testing portfolio was designed with you in mind, bringing together innovative, progressive, and flexible products and services that fuel confident and objective decision making on product quality and contamination control, ensuring the integrity of your microbial data and minimizing risk to patients. Our unparalleled portfolio keeps your manufacturing operations running efficiently, lowers your cost to manufacture, and protects your reputation.
Endosafe® Bacterial Endotoxin Testing:
Our portfolio of FDA-licensed LAL products for both rapid and traditional bacterial endotoxin testing solutions reduces retest rates, decreases variability, and improves turnaround times, enabling prompt, confident decisions about product quality and safety.
Celsis® Rapid Microbial Detection:
Celsis rapid ATP bioluminescence is quickly becoming the leading RMM for use in qualitycontrol for rapid sterility, in-process control testing, and in emerging therapeutic markets, such as mRNA-based therapies, cell therapies, gene therapies, and short shelf-life products. Rapid sterility results can be obtained in just six days, while bioburden results are available in just 24 hours.
Accugenix® Microbial Identification and Strain Typing:
Accugenix microbial identification and strain typing services offer unparalleled accuracy providing identifications that you can rely on. We process more than 450,000 environmental isolates a year, which enables us to expand our bacterial, yeast, and fungal libraries with identifying microorganisms frequently recovered from QC labs around the world. This helps us maintain relevant and robust databases for all the industries we serve.
Industries and markets served:
Biotech/pharmaceutical; Cell and gene therapy; Cleanroom facilities; Compounding pharmacy; Cosmetics; Dialysis; Food, beverage and dairy; Medical device; Nutraceuticals and dietary supplements; Personal care; Radiopharmaceutical and nuclear pharmaceutical